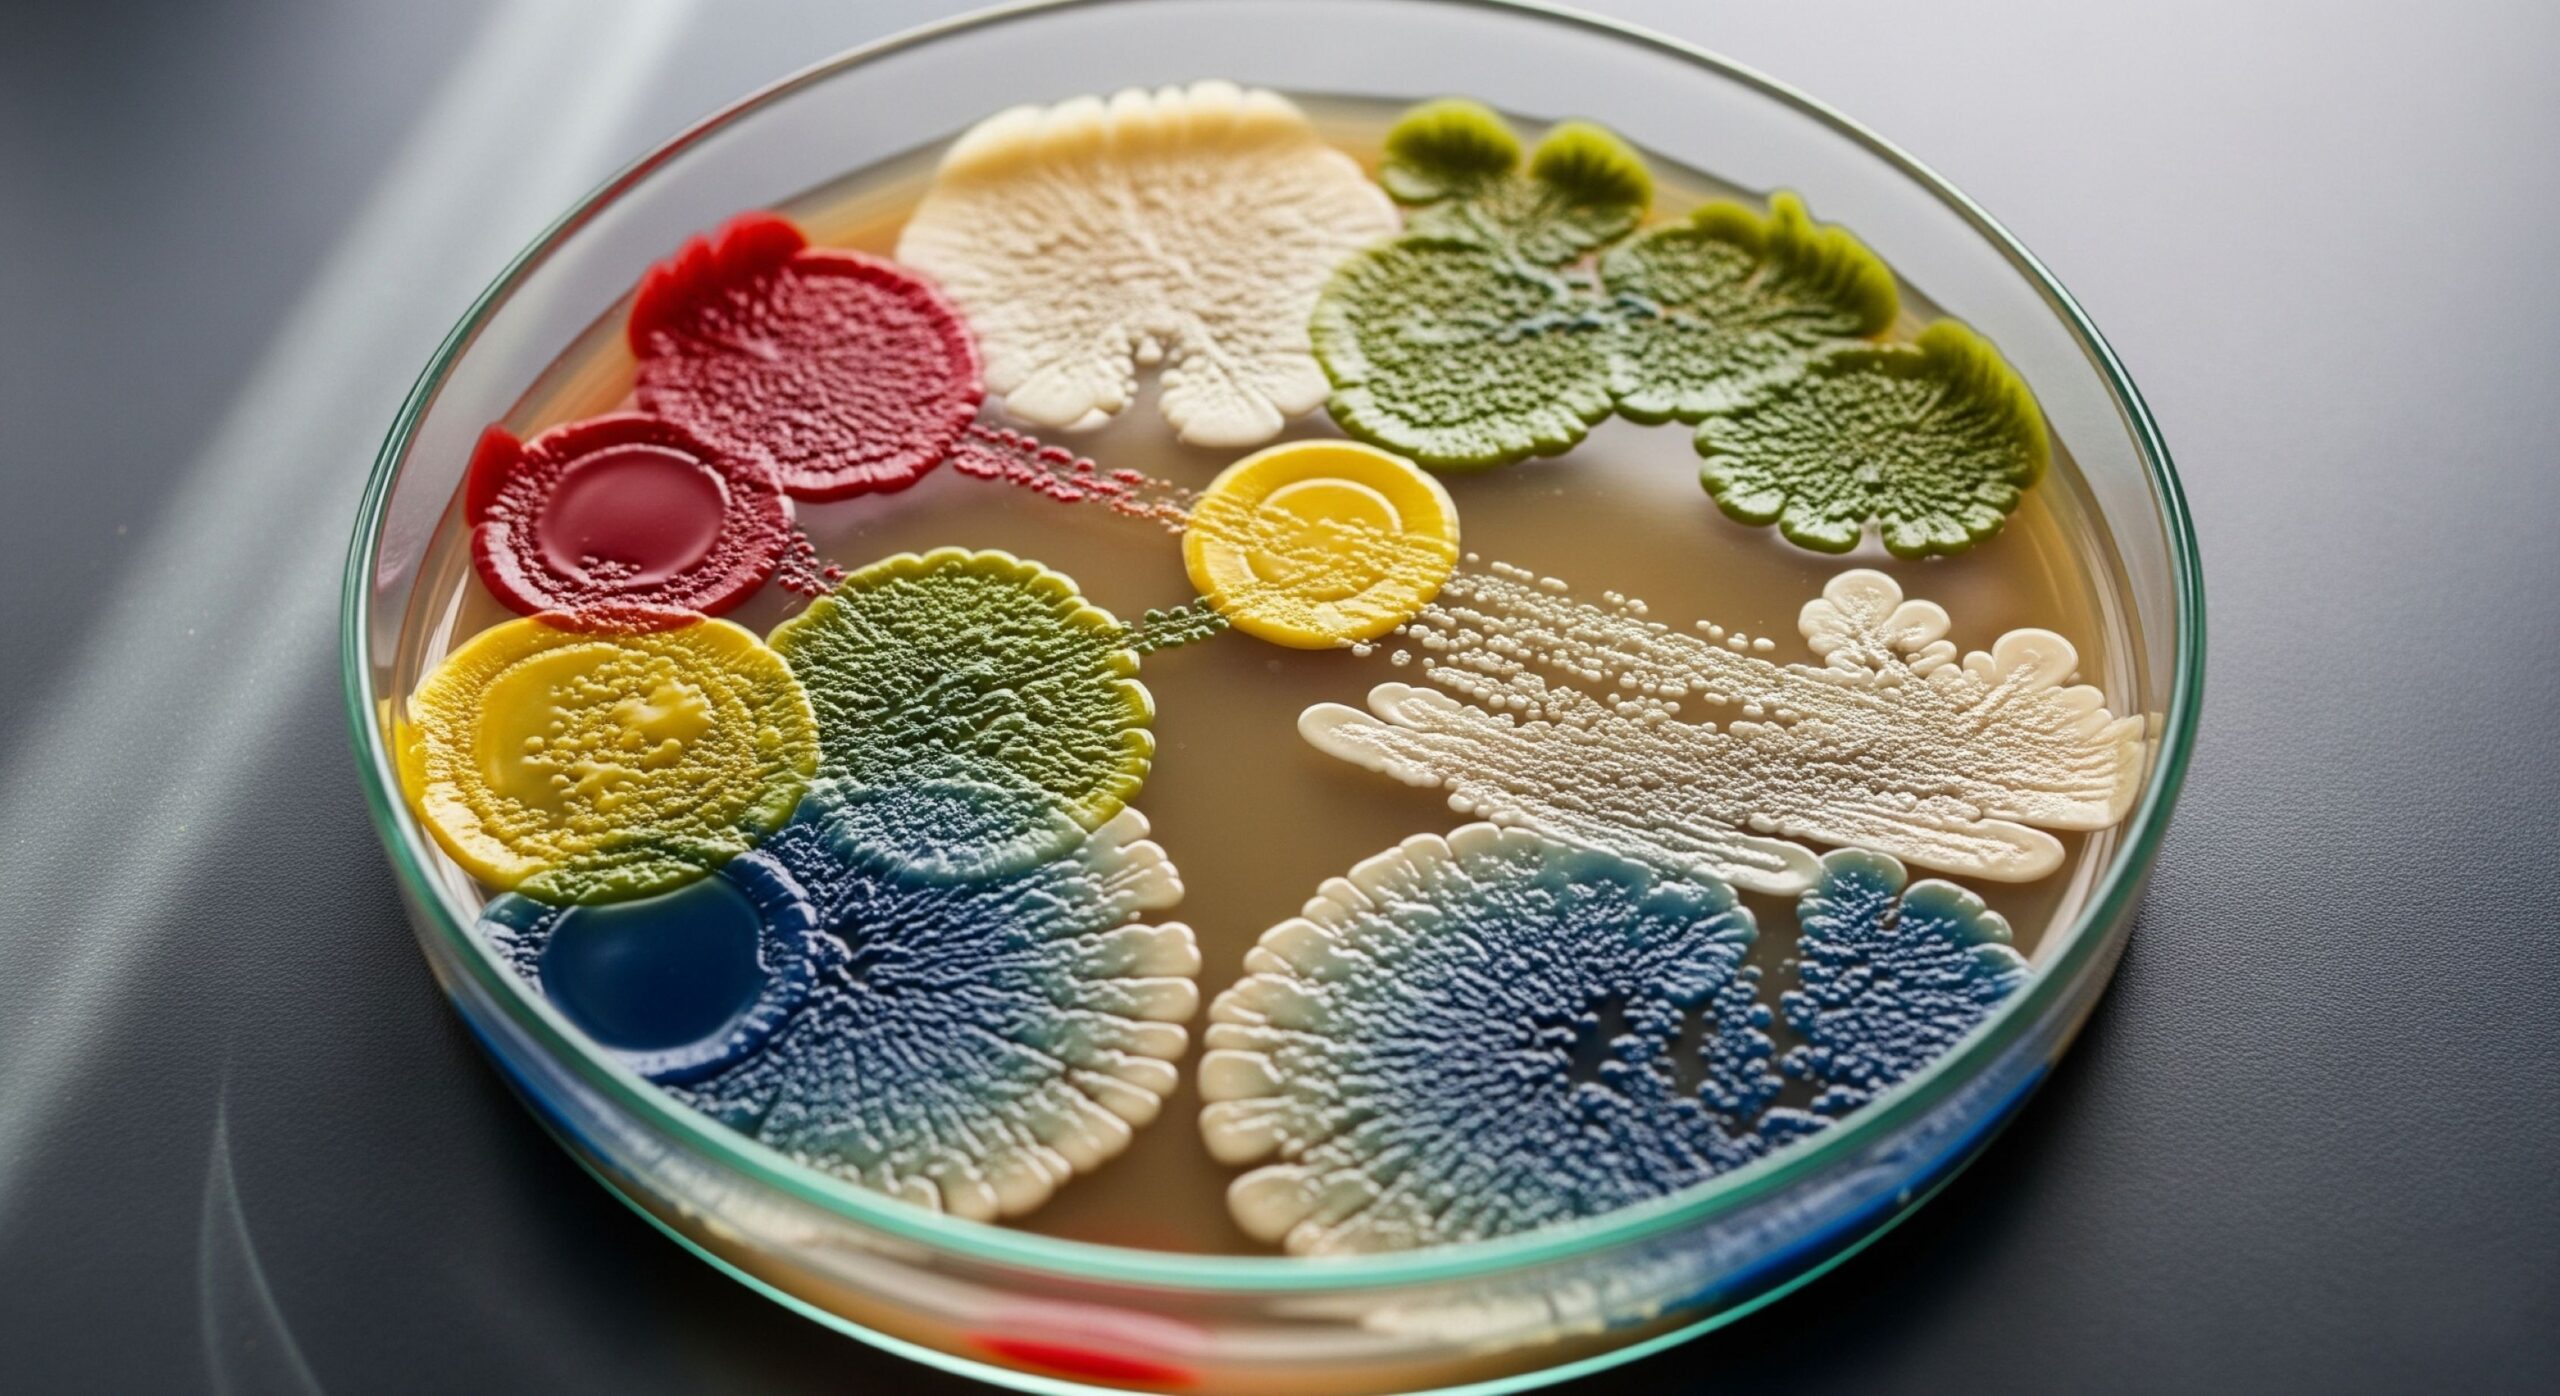
An artistic illustration of the diverse gut microbiome, showing various colorful bacteria.

If you’ve discussed heart health in the United States, you’ve likely talked about statins. For decades, this form of cholesterol treatment has been the bedrock of cardiovascular disease prevention. Doctors prescribe these drugs to millions of Americans to manage their LDL (“bad”) cholesterol. Without a doubt, they are a modern medical marvel, credited with preventing countless heart attacks and strokes. For many, a simple, once-a-day pill works silently in the background. As a result, it offers powerful protection against one of the nation’s leading killers.
But what happens when the go-to solution isn’t the right fit? Moreover, what if the simple pill narrative doesn’t match your reality? This article is your guide to a new landscape of cholesterol treatment. We will explore the full spectrum of modern options, from the role of statins to cutting-edge therapies. Ultimately, our goal is to empower you with knowledge. This way, you can have a more informed conversation with your doctor and take active control of your cardiovascular future.
The Role of Statins in Modern Cholesterol Treatment
Before we venture beyond statins, it’s crucial to understand why they are the “gold standard” for treating high cholesterol. Think of your liver as a 24/7 cholesterol factory. It constantly produces the waxy substance your body needs for building cells and hormones. Statins work by walking onto the factory floor and shutting down a key piece of machinery—an enzyme called HMG-CoA reductase. By inhibiting this enzyme, they dramatically slow your body’s cholesterol production. According to the American Heart Association, “statin medication is one of the most effective ways” to lower cholesterol. Consequently, your liver must pull more cholesterol from your bloodstream to do its job. This action effectively clears LDL from your arteries, lowering your overall levels.
However, not all statins are created equal. They come in a range of potencies, from moderate-intensity options like pravastatin to high-intensity powerhouses like atorvastatin (Lipitor). A doctor’s choice of statin and dosage depends on a person’s individual risk profile. This includes their starting LDL levels and other health conditions. For most, this approach to cholesterol treatment is incredibly effective and problem-free.
The Statin Spectrum: Not a Monolith
It’s also useful to understand that statins differ in their chemical properties. For instance, some are “hydrophilic” (water-loving) like rosuvastatin and pravastatin, while others are “lipophilic” (fat-loving) like atorvastatin and simvastatin. This difference can affect how the drugs are distributed in the body. Some research suggests that lipophilic statins, which can more easily enter various cell types, might be associated with a higher rate of certain side effects. In contrast, hydrophilic statins tend to stay more concentrated in the liver. For a patient experiencing side effects, a doctor might switch them from one type to another to see if it brings relief. This nuanced approach shows that even within the statin class, personalization is possible.
When a Statin Treatment Plan Causes Problems
Consider the case of Mark, a 58-year-old teacher from Texas. Mark was active and felt perfectly healthy. However, his annual bloodwork told a different story: his LDL cholesterol was dangerously high. His doctor prescribed a common statin. At first, Mark took it diligently to protect his health. Within a few weeks, though, something felt deeply wrong. “I felt like I was 80 years old overnight,” he recalled. “My mind was sharp, but my body just screamed ‘no’ every time I tried to move.” After a frank conversation, his doctor confirmed he had statin-associated muscle symptoms (SAMS). For Mark, the solution had become a problem, forcing them to look for alternative cholesterol treatments.

Mark’s experience is not universal, but it is far from unique. While serious side effects are rare, many patients report muscle pain, weakness, or stiffness. For these individuals, being “statin-intolerant” is a real and challenging diagnosis. In addition to muscle aches, a smaller group reports other issues, such as cognitive fogginess. It’s crucial to remember these side effects are typically not dangerous, but they can impact a person’s quality of life. Furthermore, some people simply don’t get the results they need from statins alone. This can include those with genetic conditions like familial hypercholesterolemia (FH), which causes extremely high cholesterol from birth.
Advanced Cholesterol Treatments Beyond Statins
As science has evolved, so has our arsenal against high cholesterol. Specifically, researchers have developed innovative drugs that tackle the problem from completely different angles. These aren’t always replacements for statins. Instead, they can be powerful partners or, in cases like Mark’s, essential alternatives. Think of it as moving from a single tool to a full toolkit for your cholesterol treatment plan.
Ezetimibe: A Different Approach to Cholesterol Management
One of the most common non-statins is Ezetimibe (Zetia). If statins curb production in the liver, Ezetimibe works by blocking cholesterol absorption in your intestine. It’s like placing a guard at the entrance of your bloodstream. This action prevents much of the cholesterol from your food from ever entering your system. Doctors often prescribe Ezetimibe alongside a statin for a powerful one-two punch. The landmark IMPROVE-IT trial validated this approach, showing that adding ezetimibe to a statin further reduced cardiovascular events compared to a statin alone. However, it’s also a valuable option for patients who cannot tolerate statins. On its own, it provides a modest but meaningful reduction in LDL and has a very low side-effect profile.
Injectable Cholesterol Treatments: PCSK9 Inhibitors and Inclisiran
Imagine your liver cells have tiny “hands” on their surface, called LDL receptors. These hands constantly grab bad cholesterol from the bloodstream. Therefore, the more hands you have working, the cleaner your blood. Now, imagine a pesky protein called PCSK9 that floats around destroying these hands. Fewer hands mean less cholesterol gets removed, allowing it to build up in your arteries. PCSK9 inhibitors are injectable medications (like Repatha) that act like bodyguards, neutralizing the PCSK9 protein. This frees up the LDL receptors, leading to a dramatic drop in LDL levels—often by 50-60% on top of what statins achieve.

“A landmark study concluded that for very high-risk patients, ‘evolocumab, on top of statin therapy, lowered LDL cholesterol levels by 59 percent … and reduced the risk of heart attack, stroke, or cardiovascular death.'”
— New England Journal of MedicineAnother player, Inclisiran (Leqvio), takes an even more futuristic approach. It uses RNA interference (RNAi) to “silence” the gene that makes the PCSK9 protein. In essence, it tells the liver to stop making PCSK9 in the first place, which results in a powerful and long-lasting effect. The biggest advantage for patients is convenience: after two starter doses, Inclisiran is administered just once every six months. This makes it a highly effective and low-maintenance form of cholesterol treatment.
Bempedoic Acid and Prescription Omega-3s
For those who want a daily pill but struggle with statin-related muscle pain, bempedoic acid (Nexletol) is a promising option. This “prodrug” only becomes active when it reaches the liver. Critically, the enzyme that “switches it on” is not found in muscle tissue. This brilliant biochemistry allows it to reduce cholesterol production in the liver without affecting the muscles. The recent CLEAR Outcomes trial further confirmed its value, showing it reduced major adverse cardiovascular events. Similarly, prescription Omega-3s like Vascepa target triglycerides, another fat that contributes to heart disease. They contain a highly purified form of EPA, an omega-3 fatty acid, and are FDA-approved as part of a comprehensive cholesterol treatment plan for certain high-risk patients.
Older but Relevant: Fibrates and Bile Acid Sequestrants
While newer drugs get the spotlight, some older classes of medication still have a role in specific situations. Fibrates, for example, are particularly effective at lowering high triglyceride levels and can modestly raise HDL (“good”) cholesterol. Bile acid sequestrants are another option. They work in the gut by binding to bile acids (which are made from cholesterol) and preventing their reabsorption. This forces the liver to use more LDL cholesterol from the blood to make new bile acids, thereby lowering overall levels. While they can cause gastrointestinal side effects, they are a safe option for certain patients, including some pregnant women for whom other medications may be contraindicated.

Supplements and Diet in Cholesterol Treatment
Beyond the pharmacy, your daily choices hold powerful tools for cholesterol management. While supplements aren’t regulated with the same rigor as prescription drugs, some have compelling evidence. Of course, they should only be used under a doctor’s guidance. Here are a few key players in this area of cholesterol treatment:

- Plant Sterols and Stanols: Found in fortified margarines and juices, these compounds act as decoys. They structurally resemble cholesterol and block its absorption in your gut. Consuming about 2 grams per day can lower LDL cholesterol by up to 10%.
- Red Yeast Rice: This supplement contains monacolin K, which is chemically identical to a statin. However, the NCCIH warns of inconsistent dosages and potential contaminants. For this reason, a doctor’s consultation is essential.
- Soluble Fiber: The unsung hero. Found in oats, beans, and apples, it forms a gel that traps and removes cholesterol from your body. This showcases some of the incredible health benefits of dietary fiber. Aiming for 10-25 grams of soluble fiber daily can have a real impact.
- Niacin (Vitamin B3): Once a mainstay of cholesterol treatment, high-dose niacin can lower triglycerides and raise HDL (“good”) cholesterol. Its popularity has waned, however, due to the common “niacin flush” and studies showing limited benefit when added to a statin.
- Berberine: This plant-based compound has gained attention. Early studies suggest it may help lower LDL by activating a key metabolic enzyme. While promising, more large-scale human trials are needed.
The Power of Dietary Patterns
Individual foods are important, but the overall pattern of your diet may be even more powerful. The Mediterranean Diet, for instance, emphasizes fruits, vegetables, whole grains, nuts, and olive oil. This way of eating has been consistently shown to improve all markers of heart health. Similarly, the DASH (Dietary Approaches to Stop Hypertension) diet, which focuses on low sodium and nutrient-dense foods, also has profound benefits for cholesterol and blood pressure. Adopting one of these proven dietary patterns can be one of the most effective non-pharmacological strategies in your cholesterol treatment toolkit.
“Fiber’s role in preventing heart disease is thought to stem from its ability to lower both blood pressure and cholesterol… Soluble fiber binds with cholesterol particles in the digestive system and moves them out of the body.”
— Harvard T.H. Chan School of Public HealthA Unique Perspective on Managing Cholesterol: The Gut-Heart Connection
One of the most exciting new areas of medical research is the connection between our gut microbiome and overall health. Indeed, we now know these microbes play a profound role in heart health. This is often called the gut-brain connection, which extends to the heart. For example, certain types of gut bacteria can influence how much cholesterol our bodies absorb and produce. Some beneficial bacteria can even consume cholesterol in the gut, preventing it from entering the bloodstream.
Furthermore, an unhealthy gut balance can work against us. When we eat a diet high in red meat, certain microbes produce a compound called TMAO. This compound has been linked to an increased risk of hardening arteries. You can support your gut with prebiotics and probiotics, which helps cultivate a healthier internal ecosystem. This groundbreaking research reframes heart health and cholesterol treatment as something more than just diet—it’s about how our internal ecosystem processes it.
Bonus: The Future of Cholesterol Treatment
The field of cardiology is constantly innovating. As a result, it’s moving towards an era of true personalization. The future of cholesterol management won’t just be about lowering a number on a lab report. Instead, it will be about understanding your specific, individual risk with incredible precision and tailoring therapies to match.
Beyond the Numbers: CAC Scoring for Better Cholesterol Treatment
A standard lipid panel tells you how much cholesterol is in your blood. It doesn’t, however, tell you if that cholesterol has actually started to build up in your arteries. A Coronary Artery Calcium (CAC) score does exactly that. It’s a simple, non-invasive CT scan of the heart that measures calcified plaque. A score of 0 implies very low risk, while a score over 400 implies high risk. This information can be a powerful tie-breaker. It helps doctors and patients decide how aggressively to pursue cholesterol treatment, especially for those in a borderline risk category.
The Rise of AI in Personalized Medicine
Imagine a future where your doctor can input your genetics, lifestyle, and CAC score into an AI-powered system. This system could then analyze millions of data points to predict your precise risk. Importantly, it could also predict which specific combination of medication and diet will work best for you. This is the promise of AI in medicine. It involves moving beyond population-wide guidelines to create a cholesterol treatment plan that is as unique as you are.
A “Vaccine” for High Cholesterol?
Perhaps the most revolutionary concept on the horizon is the idea of a long-term “vaccine-like” approach to cholesterol. Researchers are actively developing gene-editing therapies using technologies like CRISPR. The goal is to make a one-time, permanent change to the PCSK9 gene in the liver, effectively silencing it for life. While this is still in the experimental stage, early results have been incredibly promising. A single treatment could one day provide a lifetime of low LDL cholesterol, fundamentally changing the paradigm from daily management to a one-and-done preventative cure. This would represent the ultimate evolution in cholesterol treatment.

Conclusion: Your Personalized Cholesterol Treatment Plan
The era of a one-size-fits-all approach to cholesterol treatment is over. Today, the journey to a healthy heart is a deeply personal one. As a cardiologist at the Mayo Clinic notes, the best approach involves “weighing the risks and benefits of taking statins or other cholesterol drugs.” This underscores the need for a partnership between you and your healthcare provider, which also includes managing daily stress and other lifestyle factors.
Therefore, the key is to stay engaged and proactive. If a medication is causing side effects, speak up. If your numbers aren’t where they need to be, ask what’s next. By understanding the full range of options and working with your doctor, you can design a plan. Ultimately, this plan should not only lower your numbers but also fit your life. Committing to a complete guide to a healthy lifestyle will help protect your heart for years to come. Finally, it’s also important to learn techniques for managing daily stress to cultivate calm for overall well-being and to focus on your healthier life with simple steps.
Sources & References
- American Heart Association – Information on cholesterol medications.
- New England Journal of Medicine – Study on evolocumab and clinical outcomes.
- U.S. Food and Drug Administration – Approval information for Bempedoic Acid (Nexletol).
- National Center for Complementary and Integrative Health – Health information on red yeast rice.
- Harvard T.H. Chan School of Public Health – Details on the role of dietary fiber.
- Mayo Clinic – Discussion on weighing the benefits and risks of statins.
Cholesterol Control: A Guide Beyond Statins
The Gold Standard: Statins
Statins inhibit a key liver enzyme to reduce your body’s cholesterol production. This forces the liver to pull cholesterol from the bloodstream, effectively lowering LDL levels.
The New Wave: Non-Statin Therapies
PCSK9 Inhibitors protect liver receptors to dramatically clear bad cholesterol. Bempedoic Acid is a statin alternative that avoids muscle pain. Inclisiran offers powerful, twice-a-year treatment.
From the Aisle: Supplements & Foods
Soluble Fiber traps and removes cholesterol. Plant Sterols block absorption in the gut. Red Yeast Rice contains a natural compound similar to statins.
A Unique Perspective: The Gut-Heart Connection
New research reveals how the gut microbiome influences cholesterol absorption and production. A healthy gut ecosystem can play a profound role in cardiovascular wellness.
A Glimpse Into the Future of Care
Future treatments will be hyper-personalized. Non-invasive tests like Coronary Artery Calcium (CAC) Scoring and AI-powered diagnostics will help doctors tailor treatment plans with incredible precision.



